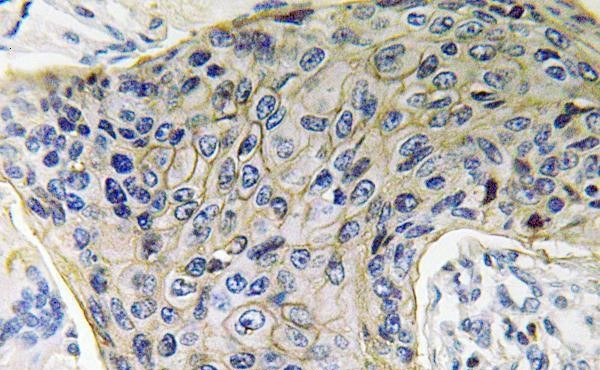
Aquaporin 4 Antibody in Immunohistochemistry (Paraffin) (IHC (P))

Search
Invitrogen
Aquaporin 4 Polyclonal Antibody
{{$productOrderCtrl.translations['antibody.pdp.commerceCard.promotion.promotions']}}
{{$productOrderCtrl.translations['antibody.pdp.commerceCard.promotion.viewpromo']}}
{{$productOrderCtrl.translations['antibody.pdp.commerceCard.promotion.promocode']}}: {{promo.promoCode}} {{promo.promoTitle}} {{promo.promoDescription}}. {{$productOrderCtrl.translations['antibody.pdp.commerceCard.promotion.learnmore']}}


Please note: We are reviewing Western blot images included in the antibody testing data in our catalog, including those provided by third parties. Unless expressly labeled or annotated as “raw-unedited”, Western blot images included in the antibody testing data in our catalog may have been edited, optimized or otherwise adjusted for presentation.
产品信息
PA5-36521
种属反应
已发表种属
宿主/亚型
分类
类型
抗原
偶联物
形式
浓度
规格
纯化类型
保存液
内含物
保存条件
运输条件
RRID
产品详细信息
This antibody detects endogenous protein at a molecular weight of 35 kDa.
Purity is >95% by SDS-PAGE.
靶标信息
In skeletal muscle, AQP4 (aquaporin 4 also known as mercurial insensitive water channel), localizes to the sarcolemma of fast-twitch muscle fibers. Aquaporins (AQPs) are a large family of integral membrane water transport channel proteins that facilitate the transport of water through the cell membrane. This function is conserved in animals, plants and bacteria. Many isoforms of aquaporin have been identified in mammals, designated AQP0 through AQP10. Aquaporins are widely distributed and it is not uncommon for more than one type of AQP to be present in the same cell. Although most aquaporins are only permeable to water, AQP3, AQP7, AQP9 and one of the two AQP10 transcripts are also permeable to urea and glycerol.
仅用于科研。不用于诊断过程。未经明确授权不得转售。
生物信息学
蛋白别名: AQP-4; aquaporin type4; Aquaporin-4; Aquaporin4; HMIWC2; Mercurial-insensitive water channel; MGC22454; MIWC; unnamed protein product; water channel; AQP4; WCH4
基因别名: AQP-4; AQP4; hAQP4; MIWC; MIWC2; MLC4; WCH4
UniProt ID: (Mouse) P55088, (Rat) P47863
Entrez Gene ID: (Human) 361, (Mouse) 11829, (Rat) 25293